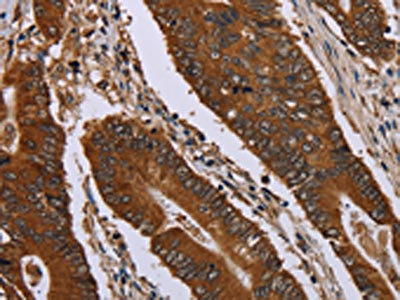

JUP Antibody
-
中文名稱:JUP兔多克隆抗體
-
貨號:CSB-PA869662
-
規格:¥1100
-
圖片:
-
The image on the left is immunohistochemistry of paraffin-embedded Human colon cancer tissue using CSB-PA869662(JUP Antibody) at dilution 1/40, on the right is treated with fusion protein. (Original magnification: ×200)
-
The image on the left is immunohistochemistry of paraffin-embedded Human lung cancer tissue using CSB-PA869662(JUP Antibody) at dilution 1/40, on the right is treated with fusion protein. (Original magnification: ×200)
-
Gel: 6%SDS-PAGE, Lysate: 40 μg, Lane 1-3: Mouse skin tissue, HUVEC cells, Hela cells, Primary antibody: CSB-PA869662(JUP Antibody) at dilution 1/850, Secondary antibody: Goat anti rabbit IgG at 1/8000 dilution, Exposure time: 10 seconds
-
-
其他:
產品詳情
-
Uniprot No.:
-
基因名:JUP
-
別名:ARVD 12 antibody; ARVD12 antibody; Catenin (cadherin associated protein); gamma 80kDa antibody; catenin (cadherin-associated protein) gamma (80kD) antibody; Catenin gamma antibody; CTNNG antibody; Desmoplakin 3 antibody; Desmoplakin III antibody; Desmoplakin-3 antibody; Desmoplakin3 antibody; DesmoplakinIII antibody; DP 3 antibody; DP III antibody; DP3 antibody; DPIII antibody; gamma catenin antibody; Junction plakoglobin antibody; JUP antibody; OTTHUMP00000164732 antibody; OTTHUMP00000164735 antibody; OTTHUMP00000164738 antibody; PDGB antibody; PKGB antibody; PLAK_HUMAN antibody; PLAKOGLOBIN antibody
-
宿主:Rabbit
-
反應種屬:Human,Mouse,Rat
-
免疫原:Fusion protein of Human JUP
-
免疫原種屬:Homo sapiens (Human)
-
標記方式:Non-conjugated
-
抗體亞型:IgG
-
純化方式:Antigen affinity purification
-
濃度:It differs from different batches. Please contact us to confirm it.
-
保存緩沖液:-20°C, pH7.4 PBS, 0.05% NaN3, 40% Glycerol
-
產品提供形式:Liquid
-
應用范圍:ELISA,WB,IHC
-
推薦稀釋比:
Application Recommended Dilution ELISA 1:2000-1:10000 WB 1:1000-1:5000 IHC 1:50-1:200 -
Protocols:
-
儲存條件:Upon receipt, store at -20°C or -80°C. Avoid repeated freeze.
-
貨期:Basically, we can dispatch the products out in 1-3 working days after receiving your orders. Delivery time maybe differs from different purchasing way or location, please kindly consult your local distributors for specific delivery time.
-
用途:For Research Use Only. Not for use in diagnostic or therapeutic procedures.
相關產品
靶點詳情
-
功能:Common junctional plaque protein. The membrane-associated plaques are architectural elements in an important strategic position to influence the arrangement and function of both the cytoskeleton and the cells within the tissue. The presence of plakoglobin in both the desmosomes and in the intermediate junctions suggests that it plays a central role in the structure and function of submembranous plaques. Acts as a substrate for VE-PTP and is required by it to stimulate VE-cadherin function in endothelial cells. Can replace beta-catenin in E-cadherin/catenin adhesion complexes which are proposed to couple cadherins to the actin cytoskeleton.
-
基因功能參考文獻:
- NEDD9, E-cadherin and gamma-catenin proteins have roles in pancreatic ductal adenocarcinoma PMID: 29924959
- gamma-Catenin acts as a tumor suppressor through context-dependent mechanisms in colorectal cancer. PMID: 28681073
- Data show that plakoglobin interacted with p53R175H and decreased beta-catenin protein levels. PMID: 29660231
- FBW7 cooperated with gamma-catenin to inhibit G2/M cell cycle transition and cell proliferation. PMID: 29408378
- These results suggest that a major role of 14-3-3gamma in desmosome assembly is to transport PG to the cell border leading to the initiation of desmosome formation. PMID: 29253567
- We showed that p53 and PG cooperatively reduced growth and acted synergistically to decrease cellular migration and invasion PMID: 27058623
- High plakoglobin expression is associated with lung adenocarcinoma. PMID: 26933815
- Knockdown of GATA6 completely eliminated the effect of TCF1, while forced expression of GATA6 induced hESC differentiation PMID: 28943339
- Studies indicate that the small molecule ICG-001 selectively blocks the cAMP response element-binding (CREB) protein (CBP)/beta-catenin or gamma-catenin interaction. PMID: 28479420
- Plakoglobin maintains the integrity of vascular endothelial cell junctions and regulates VEGF-induced phosphorylation of VE-cadherin PMID: 28158602
- In JUP mutations are the frequent cause of Arrhythmogenic cardiomyopathy, isolated Brugada syndrome can appear due to reduced sodium channel activities. PMID: 27389450
- investigated the in vitro tumor/metastasis suppressor effects of plakoglobin in ovarian cancer cell lines with mutant p53 expression and different cadherin profiles PMID: 27144941
- Reduced plakoglobin staining in intercalated discs of heart tissue from human arrhythmogenic right ventricular cardiomyopathy (ARVC) patients and in a murine ARVC model is caused by alterations in epitope accessibility and not by protein relocalization PMID: 26676851
- Idiopathic pulmonary fibrosis lung fibroblasts expressed less Pkgb protein than control fibroblasts, but characteristic fibroblast phenotypes (adhesion, proliferation, and apoptosis) were not controlled by Pkgb expression. PMID: 26545977
- Immunostaining for plakoglobin might serve as an additional diagnostic marker of arrhythmogenic right ventricular cardiomyopathy in forensic pathology. PMID: 25549959
- Expression of gamma-catenin in NSCLC cells resulted in reduced cell migration as determined by both scratch assays and trans-well cell migration assays. PMID: 25925948
- Six variants of uncertain clinical significance in the PKP2, JUP, and DSG2 genes showed a deleterious effect on mRNA splicing, indicating these are ARVD/C-related pathogenic splice site mutations. PMID: 25087486
- gamma-catenin is a tumor suppressor in esophageal squamous cell carcinoma and may serve as a prognostic marker PMID: 24914344
- Immunohistochemical analysis of plakoglobin had a relatively high sensitivity and specificity in arrhythmogenic right ventricular cardiomyopathy, but could not be relied upon as a diagnostic test for ARVC. PMID: 24294380
- extranuclear plakoglobin has a role in controlling cell adhesion via p38MAPK-dependent regulation of keratin filament organization PMID: 24441103
- Plakoglobin represses SATB1 expression and decreases in vitro proliferation, migration and invasion. PMID: 24260116
- Reduced immunoreactive signal of JUP at the intercalated disks can be observed in a majority of ARVD-C patients. PMID: 23688911
- redistribution of JUP from the cell membrane to the nucleus not only has the potential to serve as a diagnostic marker for ARVC but also might provide insights into its pathogenesis PMID: 23806441
- The combination of gamma-catenin and Twist positive staining is associated with poor prognosis in malignant pleural mesothelioma. PMID: 24457449
- data indicate that the AhR may contribute to negative regulation of Jup gene expression in rodent cellular models, which may affect cell adherence and proliferation PMID: 23690540
- analysis of the interaction between plakoglobin and CPI-17, which is affected by the phosphorylation status of CPI-17 in human lung microvascular endothelial cells PMID: 23583905
- this data suggest that plakoglobin regulates gene expression in conjunction with p53 and that plakoglobin may regulate p53 transcriptional activity, which may account, in part, for the tumor/metastasis suppressor activity of plakoglobin. PMID: 23687381
- Downregulation of catenin gamma by siRNA inhibited the proliferation and colony formation of chronic myeloid leukemia cells. PMID: 23233089
- Gamma-catenin compensates for beta-catenin loss at adherens junctions without affecting desmosomes but is unable to fulfill functions in Wnt signaling. PMID: 23555187
- A reduced immunoreactive signal of PKG, Cx43, and NaV1.5 at the intercalated disks can be observed in a large majority of the patients. PMID: 23178689
- CD133 interacts with plakoglobin and knockdown of CD133 by RNA interference (RNAi) results in the downregulation of desmoglein-2. PMID: 23326490
- Data indicate that plakoglobin and isoforms were present in atherosclerotic plaques and their secretomes. PMID: 23110151
- Overexpression of gamma-catenin is associated with stabilization and nuclear localization of beta-catenin resulting in acute myeloid leukemia. PMID: 22858986
- Data show that E-cadherin and alpha-catenin were predominantly expressed in the cell membranes, whereas beta- and gamma-catenin were found both in the cell membrane and cytoplasm. PMID: 20933443
- The presence of beta and gamma catenin, particularly in osteoblasts, demonstrates a significant role of catenins in functions such as signaling and activation of transcription factors during differentiation of bone tissues PMID: 21781455
- PG may inhibit Src by keeping VN low. Our results suggest that loss of intercellular adhesion due to reduced PG expression might be exacerbated by activation of Src through a PG-dependent mechanism PMID: 22860065
- Rnd3 regulates desmosome function and keratinocyte cell death via a plakoglobin-dependent mechanism. PMID: 22454524
- Gastroesophageal reflux disease was specifically associated with elevated transcript levels of desmoglein 2 and plakoglobin PMID: 22521077
- This study thus implicates SLUG-induced repression of plakoglobin as a motility determinant in highly disseminating breast cancer. PMID: 22496452
- Induced gene expression levels of plakoglobin, desmoglein-1 and desmoglein-2 correlated significantly with dilatation of intercellular spaces and basal cell hyperplasia in esophageal mucosa of patients with gastro-oesophageal reflux disease. PMID: 22276604
- Lack of plakoglobin in epidermis leads to keratoderma. PMID: 22315228
- the junctional protein plakoglobin is a key regulator of cell-cell contact,which may be a fundamental control mechanism governing cell viability PMID: 22046445
- The junction plakoglobin (JUP) interacts with SOX4 in both the cytosol and the nucleus and the interaction between SOX4 and plakoglobin is significantly increased when prostate and breast cancer cells are stimulated with WNT3A. PMID: 22098624
- Junction plakoglobin (JUP) interacts with SOX4 in both the cytosol and the nucleus and the interaction between SOX4 and plakoglobin is significantly increased when prostate and breast cancer cells are stimulated with WNT3A. PMID: 22098624
- Disease mechanisms, involving desmosomal proteins (such as plakoglobin) in granulomatous myocarditis, and implicating cytokines, are involved in the disruption of desmosomal proteins and arrhythmogenesis in arrhythmogenic right ventricular cardiomyopathy. PMID: 21859801
- plakoglobin and E-cadherin recruit plakophilin3 to the cell border to initiate desmosome formation PMID: 20859650
- investigation of role of gamma catenin and CBP (CREB-Binding Protein) in regulation of transcription of survivin PMID: 21158719
- sonic hedgehog-GLI1 downstream target genes PTCH1, Cyclin D2, Plakoglobin, PAX6 and NKX2.2 are differently regulated in medulloblastoma and astrocytoma PMID: 21059263
- Plakoglobin rescues adhesive defects induced by ectodomain truncation of the desmosomal cadherin desmoglein 1. PMID: 21075858
- Studies identified two mutations in DSG2, four in DSC2, two in DSP, four in JUP and seven in PKP2. PMID: 20864495
顯示更多
收起更多
-
相關疾病:Naxos disease (NXD); Arrhythmogenic right ventricular dysplasia, familial, 12 (ARVD12)
-
亞細胞定位:Cell junction, adherens junction. Cell junction, desmosome. Cytoplasm, cytoskeleton. Membrane; Peripheral membrane protein. Note=Cytoplasmic in a soluble and membrane-associated form.
-
蛋白家族:Beta-catenin family
-
數據庫鏈接:
Most popular with customers
-
-
YWHAB Recombinant Monoclonal Antibody
Applications: ELISA, WB, IHC, IF, FC
Species Reactivity: Human, Mouse, Rat
-
Phospho-YAP1 (S127) Recombinant Monoclonal Antibody
Applications: ELISA, WB, IHC
Species Reactivity: Human
-
-
-
-
-